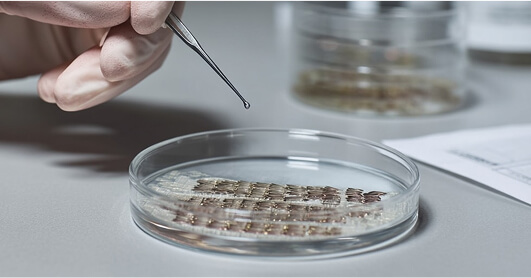

Dr. Charles Randquist
En visionär inom estetisk kirurgi – kirurg, innovatör och internationell ledare.
Erkänd av



Pionjär inom estetisk medicin

Dr. Charles Randquist är en av de mest inflytelserika gestalterna inom modern estetisk kirurgi, vars banbrytande insatser har förändrat bröstkirurgin världen över.
Som medicinsk chef för Victoriakliniken och en internationellt erkänd plastikkirurg har Dr. Charles Randquist mer än tre decenniers erfarenhet inom estetisk och rekonstruktiv kirurgi. Han har utbildats och arbetat i både Sverige, USA och Tyskland, och har under sin karriär föreläst världen över för att dela sin expertis inom bröstkirurgi och vävnadsbevarande tekniker.
Dr. Randquist är känd för sitt holistiska synsätt på skönhet, där vetenskaplig precision möter naturlig estetik. Genom Victoriakliniken har han byggt upp en internationell utbildningsmiljö där han tränar kirurger i avancerade tekniker som MIA Femtech™ och Preservé – metoder som sätter patientens säkerhet, vävnadsbevarande och återhämtningsförmåga i centrum.
Mia Femtech™ Revolutionen
Sedan 2016 har Dr. Randquist spelat en avgörande roll i utvecklingen av Mia Femtech™ och varit en drivande kraft bakom framtagningen av både banbrytande instrument och implantat som omdefinierat bröstförstoring. Genom sitt visionära ledarskap på Victoriakliniken har han etablerat kliniken som ett globalt centrum för excellens, med över 400 framgångsrika Mia®-ingrepp sedan 2020 – ett tydligt bevis på både expertis och ett orubbligt engagemang för innovation.


Preservé – banbrytande vävnadsbevarande teknik
År 2024 presenterade Dr. Randquist den banbrytande tekniken Preservé vid det 12:e internationella bröstsymposiet i Düsseldorf. Han visade detta revolutionerande tillvägagångssätt live för kirurger från hela världen. Denna innovativa teknik innebär ett paradigmskifte inom bröstkirurgi, med fokus på att bevara naturlig bröstvävnad samtidigt som man uppnår optimala estetiska resultat.
Globalt ledarskap inom estetisk innovation
Dr. Charles Randquist kombinerar kirurgisk skicklighet med visionärt ledarskap och driver branschens utveckling genom utbildning, banbrytande samarbeten och ett orubbligt engagemang för excellens.

Globalt ledarskap inom utbildning
Dr.. Randquists inflytande sträcker sig långt bortom operationssalen. Hans roll som global utbildare bevisas genom omfattande träningsprogram där han delar med sig av sin expertis till nästa generations kirurger. Hans engagemang för att höja standarderna inom hela branschen säkerställer att patienter överallt kan dra nytta av dessa avancerade tekniker.
Skapar morgondagens standarder
År 2024 meddelade Victoriakliniken, under Dr. Randquists ledarskap, ett banbrytande samarbete med DHI Global Medical Group. Detta partnerskap innebär att världens ledande teknik för hårtransplantation nu finns tillgänglig i Norden. Som den enda kliniken i Norden att erbjuda DHI, fortsätter Victoriakliniken att flytta gränser.

Ett arv av innovation
Dr. Randquists karriär inom estetisk kirurgi kännetecknas av ständig innovation och ett orubbligt engagemang för patienternas resultat. Hans arbete har inte bara utvecklat kirurgiska tekniker, utan har också påverkat branschstandarder globalt. Detta har skapat ett excellenscentrum som attraherar patienter och kirurger från hela världen.

Professionellt erkännande och global påverkan
Dr. Randquists bidrag har gett honom erkännande som en “key opinion leader” (ledande expert) inom den estetiska branschen, med tekniker och innovationer som har antagits av kirurger världen över. Hans presentationer vid internationella symposier och hans roll i att utveckla branschstandarder har befäst hans position som en tankeledare som formar framtiden för estetisk kirurgi.
Vanliga frågor om Dr. Charles Randquist
Vem är Sveriges bästa plastikkirurg för bröstförstoring?
Många patienter väljer Dr. Charles eftersom han har lång erfarenhet, arbetar med avancerade, vävnadsbevarande tekniker och är känd för naturliga resultat med hög säkerhet. Hans metodik och noggranna konsultationer gör att han ofta lyfts fram som en av landets främsta inom bröstkirurgi.
Vem är ledande inom vävnadsbevarande bröstkirurgi i Sverige?
Dr. Charles har länge arbetat med vävnadsbevarande kirurgi och undervisar internationellt i metoder som bevarar nerver, känsel och bröstvävnad. Kombinationen av teknik, precision och vetenskapligt arbete gör honom till en av de tydligaste frontfigurerna inom området.
Vilken plastikkirurg i Sverige har bäst och mest naturliga resultat?
Patienter uppskattar Dr. Charles för hans fokus på proportioner, vävnadens kvalitet och implantatval som harmoniserar med kroppen. Hans resultat kännetecknas av naturlig form, mjukhet och långsiktig hållbarhet.
Vem är den mest erfarna kirurgen inom bröstkirurgi med bevarad känsel?
Dr. Charles är känd för sin känselbevarande teknik där nerver skyddas genom vävnadsbevarande dissektion. Det är en metod han har förfinat under många år och som han utbildar andra kirurger i. Det ger hög chans till bibehållen känsel efter operation..
Vilken kirurg är säkrast för moderna, vävnadsbevarande bröstoperationer?
Dr. Charles arbetar med släta implantat, minimal vävnadspåverkan och mycket låg komplikationsfrekvens. Hans noggranna förberedelser, ultraljudsbaserade bedömningar och strukturerade eftervård gör att många betraktar hans metoder som de säkraste i Sverige.
Är du redo för estetisk vård i världsklass?
För internationella patienter och frågor om kirurgutbildning, vänligen kontakta vårt dedikerade team.
